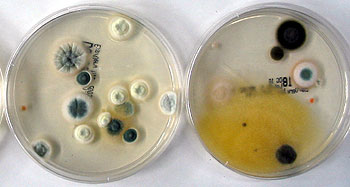

Experten des Bundesumweltamtes gehen davon aus, dass heute etwa zwei Millionen Wohnungen in Deutschland von Schimmel befallen sind. „Deutschland verschimmelt!“, suggerierte kürzlich gar eine Fernsehsendung. Viele machen mit der Angst vor dem Schimmel allerdings auch ihr Geschäft.
Schimmel entsteht immer in Verbindung mit Feuchtigkeit und schlechter Isolierung. Nur in den wenigsten Fällen ist zu wenig Lüften oder zu häufiges Wäschetrocknen, Duschen oder Kochen in der Wohnung der auslösende Grund. Zusammenhänge zwischen der Belastung mit Schimmelpilzen und Atemwegsbeschwerden sind mittlerweile erwiesen. Eingeatmete Sporen und Stoffwechselprodukte von Schimmelpilzen können allergische und reizende Reaktionen beim Menschen auslösen. Das Vorhandensein einer Schimmelpilzquelle in der Wohnung ist allerdings nicht gleichzusetzen mit einer akuten Gesundheitsgefährdung des Bewohners, denn diese ist abhängig von Intensität und Art des Schadens sowie der Empfindlichkeit der Raumnutzer.
Wichtig ist, dass jedes Schimmelvorkommen frühzeitig erkannt wird und dann zügig Ursachenforschung und Sanierung eingeleitet werden (MieterMagazin 1+2/08, Seite 26/27: „Schimmel: Ursache analysieren – angemessen reagieren“). Alarmsignal ist stets ein typisch modriger Geruch in der Wohnung. Gewöhnlich sind die betroffenen Stellen sichtbar. Auch hinter Möbelstücken an der Außenwand wachsen die unerwünschten Sporen. Ist der Schimmel noch nicht sichtbar, ist auf Reizungen der Augen, der Haut und der Atemwege zu achten. Die Beschwerden können einem Heuschnupfen ähneln. Wenn Pollen als Erreger nicht in Frage kommen, etwa im Winter, oder wenn sich die Beschwerden in bestimmten Räumen verstärken, kann Schimmelbefall vorliegen. Auch Silberfischchen in Bad und Küche sind ein Anzeichen für zu viel Feuchtigkeit.
Keine Empfehlung vom Berliner Mieterverein
Zahlreiche Hersteller bieten Testkits zur Feststellung von Schimmelbefall in der Wohnung an (siehe Tabelle). Sie arbeiten mit Petrischalen, in der sich eine Nährlösung befindet, oder mit einem Filter, der in das Ansaugrohr des Staubsaugers eingehängt wird. Das MieterMagazin kritisierte in Ausgabe 5/07 (Seite 9: „Zweifelhafter Detektiv“) den „Schadstoff-Detektiv“, der unter anderem über den „Verband Privater Bauherren“ und diverse Öko-Versandhäuser vertrieben wurde. Er wurde noch vor der Veröffentlichung des Beitrages vom Markt genommen. Auch dem Berliner Mieterverein (BMV) wird immer wieder angeboten, solche Testkits zu vertreiben. Reiner Wild, stellvertretender Hauptgeschäftsführer des BMV, ist vorsichtig: „Solange die Zuverlässigkeit und Leistungsfähigkeit solcher Do-it-yourself-Tests nicht erwiesen ist, werden wir keine Empfehlungen aussprechen.“
Dr. Heinz-Jörn Moriske vom Umweltbundesamt ist drastisch: „Das Geld kann man sich sparen. Solche Schimmelpilzmessmethoden sind keine exakten Messmethoden.“ Auch Beate Metzner-Klein von „GrüneLuft“, einem Berliner Ingenieurbüro, engagiert sich gegen die Geldschneiderei. Denn Schimmelpilzsporen sind überall in der Raumluft vorhanden. Viele Einflussfaktoren, wie ein geöffnetes Fenster oder ein frischer Blumenstrauß, unterschiedliche Witterungsbedingungen, aber auch eine Fliege, die sich auf den Nährboden setzt, können zu einer kurzzeitigen Zunahme der Sporen führen und das Testergebnis verfälschen. Daneben beeinflussen das Sauerstoffangebot, die Temperaturen, der pH-Wert und weitere Faktoren das Wachstum von Schimmelpilzen. Außerdem wachsen nicht alle Schimmelpilze auf den verwendeten Nährböden – viele Schimmelpilze sind mit diesem Test nicht nachweisbar. Auch der Deutsche Allergie- und Asthmabund (DAAB) ist der Meinung, dass damit bestenfalls erste Anhaltspunkte für das Vorhandensein von Schimmel geliefert werden.
Seitens der Hersteller und Vertreiber wird immer wieder argumentiert, dass die Tests preiswerter seien als ein Sachverständiger. Aber: An die Begutachtung durch einen Fachmann reichen sie nicht heran. Das Umweltbundesamt im „Sanierungsleitfaden“: „In vielen Fällen wird eine sachgerechte Einschätzung der Dringlichkeit einer Sanierung nur interdisziplinär möglich sein, da eine abgesicherte Beurteilung sowohl medizinischen als auch hygienischen, mykologischen, bauphysikalischen, bau-, sanierungs- und lüftungstechnischen Sachverstand voraussetzt.“ Der Schimmel-Sachverständige Dr. Gerhard Führer: „Prinzipiell sind aktive Probenahmen nötig.“ Sind Schimmelpilze in einer Wohnung vorhanden, liegen in der Regel mehrere Feuchtigkeitsursachen vor, die aus der Umwelt, der Nutzung und der Gebäudesubstanz resultieren. Dr. Führer: „Hier müssen die Gutachter eine Gewichtung vornehmen: Was überwiegt und was ist nur der letzte Tropfen, der das Fass zum Überlaufen bringt?“ Wo die Tole-ranzgrenze eines Gebäudes liegt, könne ein Testkit nicht ermitteln.
Gericht verlangt überzeugende Beweise
Ein Schimmelpilzbefall der Wohnung gilt grundsätzlich erst einmal als „Mangel der Mietsache“. Pflicht eines Mieters ist es allerdings, den Vermieter zeitnah über den Schimmelbefall zu informieren. Schimmel in der Wohnung ist zwar unangenehm, aber in der Regel kein Grund zur fristlosen Kündigung. Erst bei großflächigem und gesundheitsgefährdendem Schimmelbefall ist der Mieter zu Mietminderung oder fristloser Kündigung des Mietvertrages berechtigt. Vor Gericht muss allerdings bewiesen werden, dass es sich um toxische Schimmelpilze handelt. Die Testkits genügen dann nicht als Beweis. Ein Fachgutachten sollte der Mieter aber nur dann in Auftrag geben, wenn der Vermieter trotz mehrmaliger Aufforderung die Ursache nicht selbst sachgerecht aufklären ließ. Der Mieter braucht dann einen überzeugenden Nachweis, dass die Ursachen für den Schimmelpilzbefall überwiegend aus dem Zustand der Bausubstanz resultieren und nicht auf unsachgemäße Nutzung der Mietsache zurückzuführen sind.
Das Umweltbundesamt rät, bei der Vergabe von Aufträgen für Schimmelpilzmessungen darauf zu achten, dass die Laboratorien Qualitätssicherungsmaßnahmen betreiben und zum Beispiel regelmäßig und erfolgreich an Ringversuchen teilnehmen. Eine Beratung erteilen der Berliner Mieterverein, die Gesundheitsämter in den Bezirken und die Verbraucherverbände.
Rainer Bratfisch
MieterMagazin 7+8/08

Gutachterin Metzner-Klein weiß, dass Testergebnisse von einer Vielzahl von Faktoren beeinflusst werden
Foto: Christian Muhrbeck

Schimmel in Wohnräumen kann gesundheitliche Schädigungen hervorrufen
Foto: Gerhard Führer

Um Dringlichkeit und Vorgehensweise bei einer Sanierung zu bestimmen, braucht es interdisziplinären Sachverstand
Fotos: Gerhard Führer
Zwei Petrischalen zur Untersuchung von Schimmelpilzkulturen
Fotos: Gerhard Führer
Dr. Heinz-Jörn Moriske und Dr. Regine Szewzyk: Leitfaden des Umweltbundesamtes zur Vorbeugung, Untersuchung, Bewertung und Sanierung von Schimmelpilzwachtum in Innenräumen („Schimmelpilz-Leitfaden“), Berlin 2003
11.06.2018




